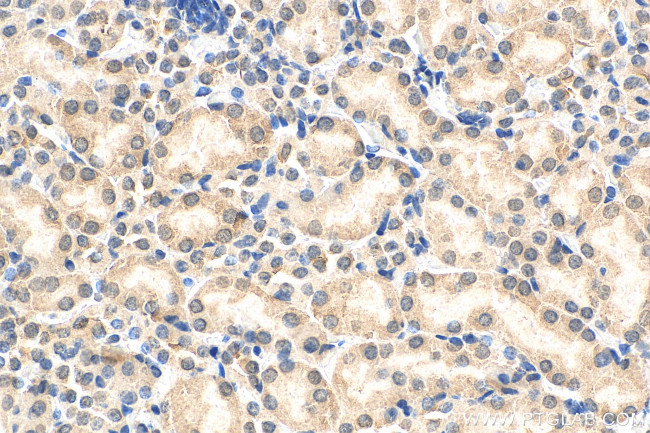
HSPBAP1 Antibody in Immunohistochemistry (Paraffin) (IHC (P))

Search
Proteintech
HSPBAP1 Polyclonal Antibody
{{$productOrderCtrl.translations['antibody.pdp.commerceCard.promotion.promotions']}}
{{$productOrderCtrl.translations['antibody.pdp.commerceCard.promotion.viewpromo']}}
{{$productOrderCtrl.translations['antibody.pdp.commerceCard.promotion.promocode']}}: {{promo.promoCode}} {{promo.promoTitle}} {{promo.promoDescription}}. {{$productOrderCtrl.translations['antibody.pdp.commerceCard.promotion.learnmore']}}
产品信息
27771-1-AP
种属反应
宿主/亚型
分类
类型
抗原
偶联物
形式
浓度
纯化类型
保存液
内含物
保存条件
运输条件
产品详细信息
Immunogen sequence: IELEEDHLA RVEEAITRML VCALKTAENP QNTRAWLNPT EVEETSHAVN CCYLNAAVSA FFDRCRTSEV VEIQALRTDG EHMKKEELNV CNHMEVGQTG SQNLTTGTDK PEAASPFGPD LVPVAQRSEE PPSERGGIFG SDGKDFVDKD GEHFGKLHCA KRQQIMSNSE NAIEEQIASN (273-451 aa encoded by BC011897)
靶标信息
HSPBAP1 (HSPB (heat shock 27kDa) associated protein 1), also known as PASS1 (protein associated with small stress protein 1), is a 488 amino acid cytoplasmic protein that contains one JMJC (Jumonji C) domain and shares 80% identity with its rat homolog, PASS1. Widely expressed with highest expression in ovary, thymus and pancreas, HSPBAP1 is thought to play a role in mediating cellular stress responses within the cell. Due to the presence of a JMJC domain, HSPBAP1 may be involved in chromatin remodeling events. Defects or translocations in the gene encoding HSPBAP1 are associated with renal cell carcinoma 1 (RCC1), suggesting a possible role for HSPBAP1 in carcinogenesis. Three isoforms of HSPBAP1 exist due to alternative splicing events.
仅用于科研。不用于诊断过程。未经明确授权不得转售。
篇参考文献 (0)
生物信息学
蛋白别名: 27 KdA heat shock protein-associated protein 1; FLJ22623; FLJ39386; Heat shock protein; HSP; HSP27; HSP28; HSPB (heat shock 27kDa) associated protein 1; HSPB1-associated protein 1; Protein associated with small stress protein 1; protein associating with small stress protein PASS1; UG1259C02; unnamed protein product
基因别名: 3830421G21Rik; HSPBAP1; PASS1
UniProt ID: (Human) Q96EW2, (Mouse) Q8BK58
Entrez Gene ID: (Human) 79663, (Mouse) 66667